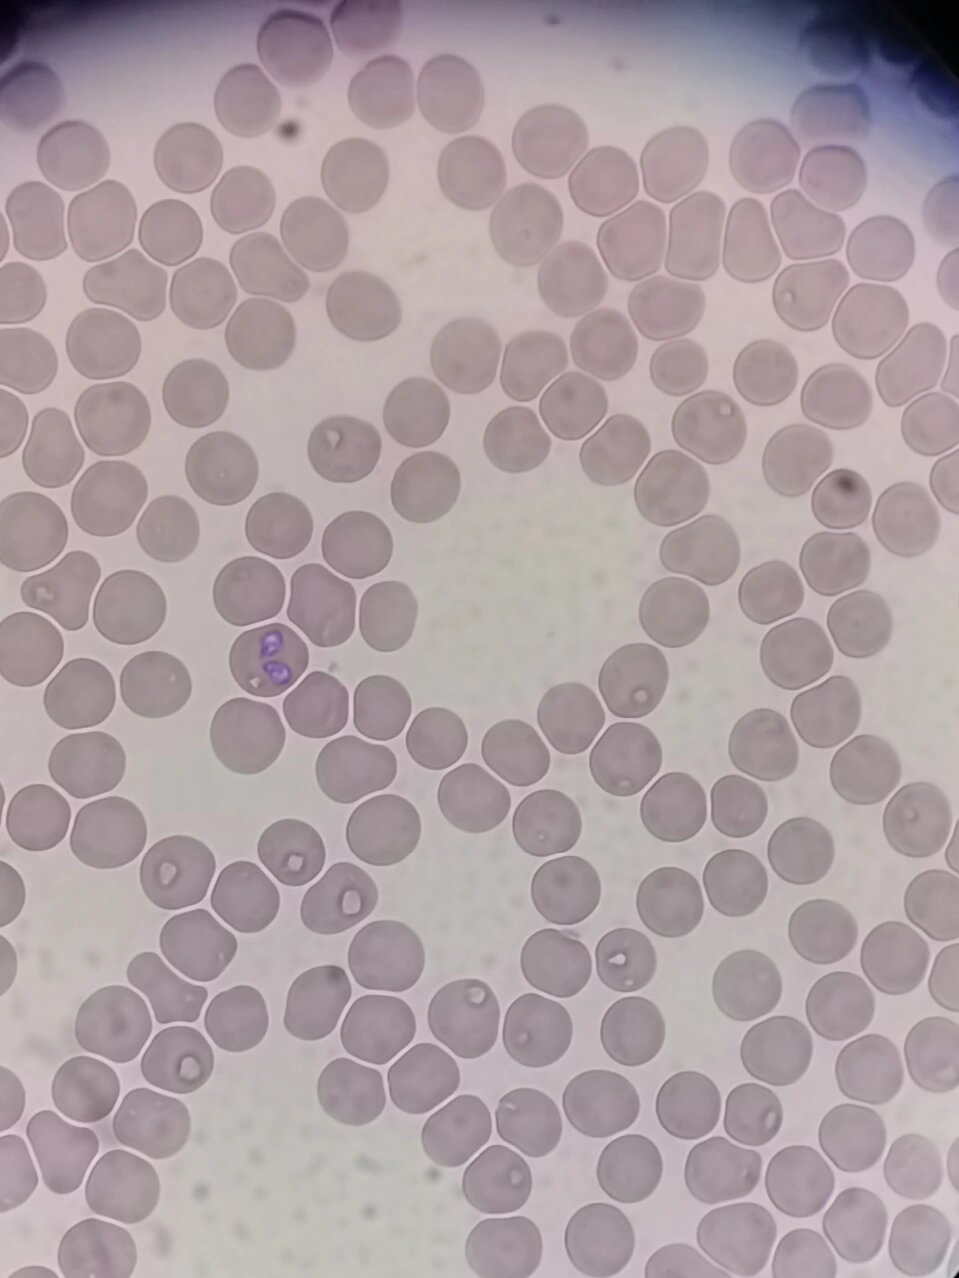
犬巴贝斯虫 犬巴贝斯虫又称梨形虫,由蜱虫传播导致的血液寄生虫,感染

犬巴贝斯虫

🐕🔬 犬巴贝斯虫病:宠物健康的新挑战
图片尺寸1024x786
犬吉氏巴贝斯虫病:狗狗的健康杀手 🐶🔥 犬巴贝斯虫病是一种由硬
图片尺寸1031x733
狗狗巴贝斯虫病:户外驱虫是关键!
图片尺寸1080x1118
犬巴贝斯虫 犬巴贝斯虫又称梨形虫,由蜱虫传播导致的血液寄生虫,感染
图片尺寸959x1278
狗狗巴贝斯虫病:症状,治疗与预防全攻略
图片尺寸1080x1410
犬巴贝斯虫:蜱虫传播大威胁
图片尺寸1170x1140
🐕🔬 犬巴贝斯虫病:宠物健康的新挑战
图片尺寸1024x761
狗狗巴贝斯虫,一文解析!
图片尺寸1618x3065
巴贝斯虫
图片尺寸1440x2700
揭秘犬巴贝斯虫:症状,诊断与治疗全攻略
图片尺寸1633x2130
🐕🔬 犬巴贝斯虫病:宠物健康的新挑战
图片尺寸1242x1630
犬巴贝斯虫病是一种由犬巴贝斯虫引起的血液原虫病,这种虫子寄生在
图片尺寸1440x1890
blank" href="/item/犬巴贝斯虫病/12604181"
图片尺寸1024x768
🐾 犬巴贝斯虫病:预防与治疗全攻略 💉
图片尺寸917x994
🐾 犬巴贝斯虫感染全解析 🔍
图片尺寸826x526
犬巴贝斯虫病:春季宠物健康大敌
图片尺寸966x1273
夏季宠物驱虫必备:了解犬巴贝斯虫
图片尺寸1440x1808
犬巴贝斯虫病的全面防治策略
图片尺寸544x248
🐾犬巴贝斯虫病:蜱虫传播的威胁🐛
图片尺寸400x943
🐾犬巴贝斯虫病:蜱虫传播的威胁🐛
图片尺寸580x554